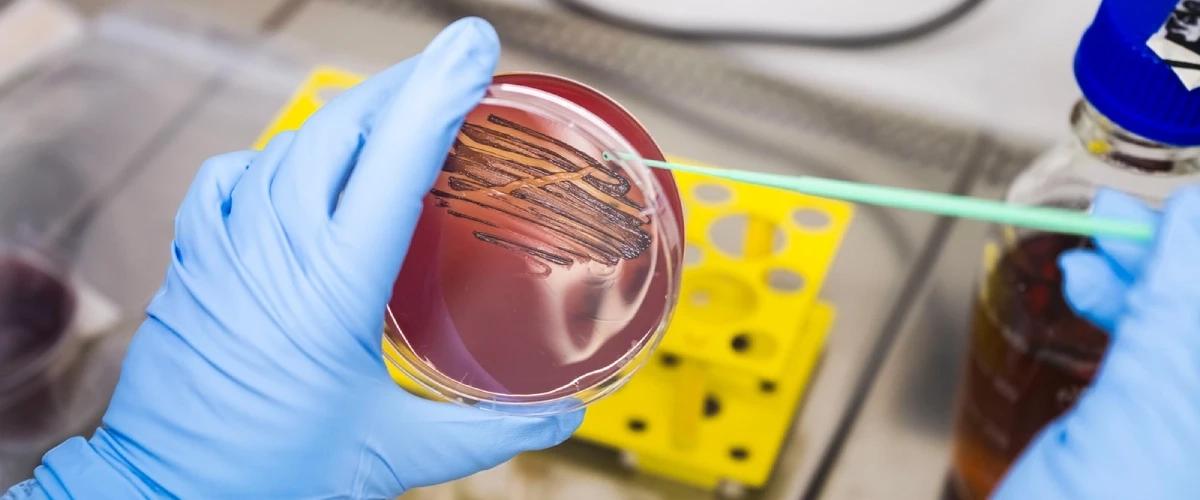
TODO:

Создание зубной пасты базируется на открытии вещества, которое избирательно блокирует только вредные бактерии, такие как porphyromonas gingivalis. Основное преимущества нового соединения в том, что оно не только убивает возбудителя гингивита (начальной стадии пародонтоза), но и подавляет рост бактерий, сообщается на сайте Института клеточной терапии и иммунологии им. Фраунхофера.
«Таким образом, вещество работает в гармонии со здоровыми бактериями, мягко восстанавливая и стабилизируя микробиоту полости рта», — заявил автор работы Штефан Шиллинг. Такой механизм действия особенно важен, поскольку после применения современных ополаскивателей, в том числе на основе хлоргексидина, патогенные бактерии начинают расти в полости рта намного быстрее полезных.
Пока авторы работают над совершенствованием состава, который также будет включать все необходимые для такого продукта вещества. Помимо пасты они также работают над созданием защитного геля и ополаскивателя, которые позволят сохранить баланс микробиоты полости рта.
Недавно в другом исследовании ученые выяснили, что кариес и заболевания десен повышают риски инсульта почти на 90%.